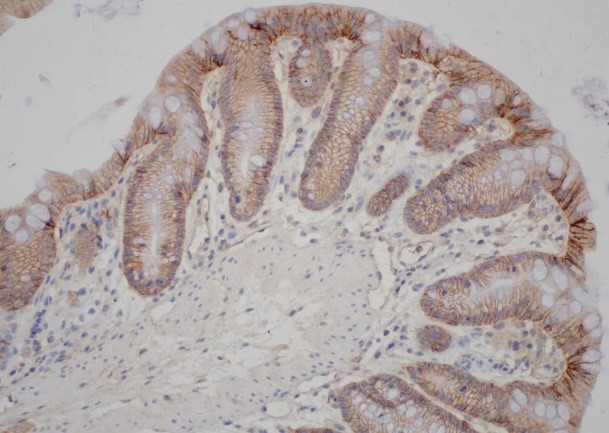
Rabbit Polyclonal Antibody to Claudin 1

提醒成功

搜索
Rabbit Polyclonal Antibody to Claudin 1
-
货号:
P23636 -
别名:
CLDN1; CLD1; SEMP1; Claudin-1; Senescence-associated epithelial membrane protein -
应用:
WB,IHC,IF -
反应种属:
Human,Mouse,Rat -
抗体类型:
Primary antibody -
Swissprot:
O95832 -
规格:
-
数量:
-+ -
说明书:
目录价¥1980

Rabbit Polyclonal Antibody to Claudin 1
Description |
|---|
The claudin family is composed of 23 integral membrane proteins, and their expression, which varies among tissue types, may determine both the strength and properties of the epithelial barrier. Alteration in claudin protein expression pattern is associated with several types of cancer. Claudin-1 is expressed primarily in keratinocytes and normal mammary epithelial cells, but is absent or reduced in breast carcinomas and breast cancer cell lines. |
Specification |
|
|---|---|
| Aliases | CLDN1; CLD1; SEMP1; Claudin-1; Senescence-associated epithelial membrane protein |
| Entrez GeneID | 9076 |
| Swissprot | O95832 |
| WB Predicted band size | Calculated MW: 23 kDa; Observed MW: 23 kDa |
| Host/Isotype | Rabbit IgG |
| Antibody Type | Primary antibody |
| Storage | Store at 4°C short term. Aliquot and store at -20°C long term. Avoid freeze/thaw cycles. |
| Species Reactivity | Human,Mouse,Rat |
| Immunogen | The antiserum was produced against synthesized peptide derived from human Claudin 1. AA range:162-211 |
| Formulation | Purified antibody in PBS with 0.05% sodium azide,0.5%BSA and 50% glycerol. |
Application |
|
|---|---|
| WB | 1/500-1/1000 |
| IHC | 1/50-1/100 |
| IF/ICC | 1/50-1/200 |
| ELISA | 1/10000 |
Product Image
- Western blot analysis of Claudin 1 in Hela lysates using Claudin 1 antibody.
- Western blot analysis of Claudin 1 in HeLa lysates using Claudin 1 antibody. The lane on the right is blocked with the synthesized peptide.
- Immunohistochemistry analysis of paraffin-embedded Human breast carcinoma tissue, using Claudin 1 antibody.High-pressure and temperature Sodium Citrate pH 6.0 was used for antigen retrieval. Sample with blocking peptide on the right.
- Immunohistochemistry analysis of paraffin-embedded Mouse Colon tissue, using Claudin 1 antibody.High-pressure and temperature Tris-EDTA pH 9.0 was used for antigen retrieval.
- Immunohistochemistry analysis of paraffin-embedded Mouse Colon tissue, using Claudin 1 antibody.High-pressure and temperature Tris-EDTA pH 9.0 was used for antigen retrieval.
For Reseach Only
Application Key:WB - Western Blot | IHC - Immunohistochemistry | ICC - Immunocytochemistry | FCM - Flow Cytometry | ELISA - Enzyme-linked Immunosorbent Assay | IP - Immunoprecipitation
#P23636

相关产品















 微信/QQ登录
微信/QQ登录


 首页
首页